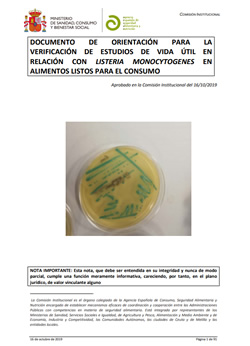
Listeria monocytogenes verificación de estudios de vida útil en ALC

La Agencia Española Seguridad Alimentaria y Nutrición (AESAN) ha publicado un documento de orientación para empresas alimentarias de productos listos para el consumo, que describe un procedimiento para verificar la adecuación de los obligatorios estudios de vida útil de sus productos, y comprobar si la documentación de dichos estudios es adecuada y suficiente para controlar la presencia de Listeria monocytogenes.
Los alimentos listos para el consumo (ALC) se consideran entre los de mayor riesgo de transmisión de Listeria monocytogenes. Por lo que es crucial que los productores de ALC lleven a cabo las acciones necesarias para controlar tanto la contaminación por Listeria monocytogenes durante los procesos de fabricación y manipulación, como su crecimiento en el producto final hasta el final de su vida útil, de modo que sus productos no supongan un riesgo potencial para la salud pública.
La vida útil de un alimento se considera el período de tiempo en el que éste sigue siendo seguro y cumple sus especificaciones de calidad, en las condiciones de almacenamiento y uso previstas. La vida útil determina la fecha de caducidad y se expresa como “fecha de caducidad” o “consumir preferentemente antes de". La definición de un periodo de vida útil realista para los ALC que pueden favorecer el crecimiento de Listeria monocytogenes es muy importante para garantizar su seguridad.
Sin embargo, en este tipo de alimentos es difícil predecir con un alto grado de certeza si el nivel de contaminación durante la vida útil será o no, superior al criterio microbiológico de 100 ufc/g que establece el Reglamento (CE) nº 2073/2005, sobre todo debido a la importante variación en las condiciones de almacenamiento (tiempo y temperatura) en el ámbito doméstico.
Orientación para la verificación de los estudios de vida útil en ALC
La Agencia Española Seguridad Alimentaria y Nutrición (AESAN) ha publicado el Documento de orientación para la verificación de estudios de vida útil en relación con Listeria monocytogenes en alimentos listos para el consumo, para apoyar a las Autoridades Competentes en la verificación de que los estudios de vida útil, que están legalmente obligados a realizar los explotadores de empresas alimentarias responsables de la fabricación, envasado y/o reenvasado de Alimentos Listos para el Consumo (ALC), son idóneos.
En este documento se describe un procedimiento para verificar si la documentación aportada por el operador es adecuada en cuanto al tipo de estudios de vida útil realizados y las condiciones en los que se han llevado a cabo (variabilidad inherente de productos, microorganismos y condiciones de transformación y almacenamiento), y también si es suficiente, es decir, si puede demostrar que el producto cumple el criterio microbiológico establecido durante toda su vida útil. Se contemplan por separado los estudios de vida útil realizados por las propias empresas y los realizados por colaboración entre empresas.
Se incluye un apartado de categorías de ALC que pueden favorecer o no el desarrollo de Listeria monocytogenes, de acuerdo con lo establecido en el anexo I del Reglamento (CE) Nº 2073/2005 y, finalmente, el documento de orientación contiene cuatro Anexos, con las especificaciones de los distintos tipos de estudios de vida útil, la tecnología de los obstáculos o de barreras, un árbol de decisiones para la clasificación de los alimentos en los grupos establecidos en el Reglamento (CE) Nº 2073/2005 y un listado de revisión para que los inspectores de control oficial puedan chequear el cumplimiento de distintos requisitos de los estudios presentados.
Documento de orientación para la verificación de estudios de vida útil en relación con Listeria monocytogenes en alimentos listos para el consumo, AECOSAN, octubre 2019

Higiene Ambiental Consulting, junto con Ambientalys, hemos desarrollado una formación técnica especializada, con el objetivo de formar acerca de cómo se desarrolla esta bacteria dentro de la industria alimentaria, dar a conocer las estrategias, técnicas y productos para controlarla y aprender a identificar los sistemas de detección y prevención más adecuados.
Esta formación se imparte en modalidad on-line y tiene una duración de 25 horas.
Más información sobre el Curso on-line: Listeria: prevención y control en la industria alimentaria